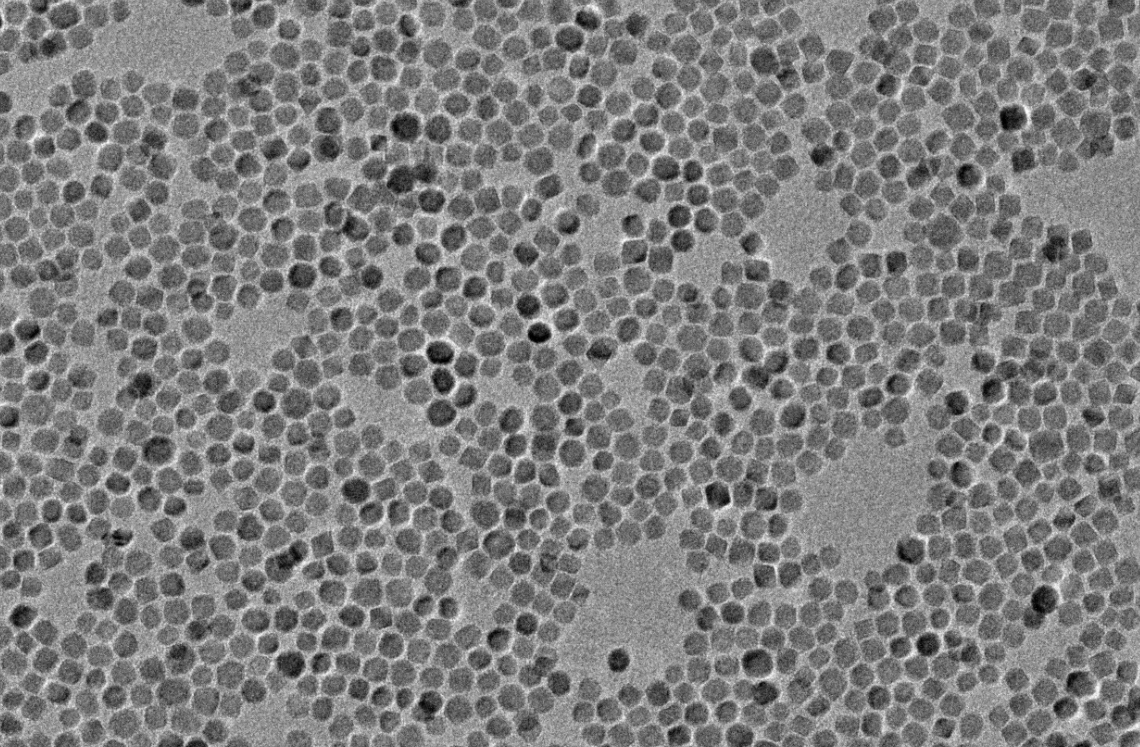

油酸修饰四氧化三铁的制备方法,油酸修饰磁性纳米颗粒的作用
行业知识
/ 2023-01-30 10:34:33
油酸修饰磁性纳米颗粒是什么?
四氧化三铁纳米颗粒通过表面修饰过程可以降低磁性纳米粒子的表面能,从而改善提高磁性纳米粒子的分散性,还可以通过特定的修饰方法引入功能性基团实现磁性纳米微粒的功能化。
油酸修饰的磁性Fe3O4纳米颗粒(OA@Fe3O4),具有优异的磁性、分散性和稳定性,可广泛应用于纳米探针构建、磁共振造影与分子影像、磁热疗、药物载体及靶向诊疗一体化研究等。
油酸修饰的四氧化三铁磁性纳米颗粒制备方法主要有:
微乳液法、水热合成法、热分解铁有机物法、化学共沉淀合成法、凝胶-溶胶法等。
油酸修饰四氧化三铁磁性纳米颗粒的成分
OA@Fe3O4、氯仿
油酸修饰四氧化三铁磁性纳米颗粒的性状
- 棕色澄清胶体
- 固体粉末
油酸修饰四氧化三铁磁性纳米颗粒的大小
粒径有:5nm 10nm 20nm 30nm 40nm 50nm
油酸修饰四氧化三铁磁性纳米颗粒的用途
用于掺杂水包油纳米乳、修饰纳米脂质体、构建磁性纳米药物等
油酸修饰四氧化三铁磁性纳米颗粒的特点
- 表面修饰油酸、油胺
- C顺磁性
- 环保无污染
- 磁共振成像对比增强 效果佳
- 分散性、稳定性佳
油酸修饰四氧化三铁磁性纳米颗粒的保存方法
密封,4℃长期保存,切勿冻存
中科科优是纳米材料的销售、研发、制造、应用服务于一体的高科技型企业。目前中科科优已与多所科研院校、航空航天单位及众多生产制造企业建立了长期合作关系。产品涵盖羧基磁珠、氨基磁珠、油胺修饰磁珠、PEG修饰磁珠、无修饰四氧化三铁磁珠、单分散硅包磁、环氧基磁珠、单分散介孔硅包磁、金包磁性纳米颗粒、硅羟基磁珠、链霉亲和素修饰磁珠、多聚赖氨酸修饰磁珠、镍磁珠、磁性聚苯乙烯微球、二氧化硅磁性微球等。产品种类齐全,可以满足各类客户研发、试验及生产、消费等不同个性化材料需求,多年来得到了广大用户的普遍信赖。
最新动态
- 单分散微球的种类和应用领域。 2023-06-23 20:40:23
- 纳米金都有哪些?纳米金粉、金纳米颗粒、金纳米粒子、金纳米胶体等的颜色和形态。 2022-05-24 17:18:10
- 纳米铂金的作用及功效 2021-12-28 14:04:07
- 各种形态的银。纳米银粉片状银纳米银线银溶液的颜色粒径及应用 2022-02-26 13:34:02
- 乳胶微球常见问题 2023-02-07 11:25:14
- 磁性纳米材料的的性质与应用 2022-12-21 10:32:35
- 磁珠的保存法,磁珠的保存条件。磁珠使用注意事项。 2022-11-30 10:48:16
- 重组荧光蛋白的优势 2026-06-12 15:46:10
- 中科科优金溶胶拉曼增强试剂在FL‑SERS 双模式铅离子传感中拉曼测试的核心支撑 2026-05-18 09:21:59
- 球形纳米氧化铈的用途。 2026-05-12 11:42:05